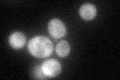
YDR477W
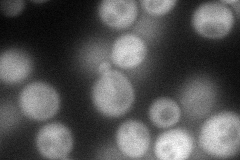
YDR477W
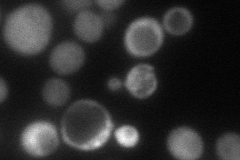
YDR477W
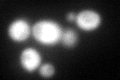
YDR477W
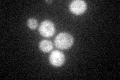
YDR477W

View description
AMP-activated serine/threonine protein kinase found in a complex containing Snf4p and members of the Sip1p/Sip2p/Gal83p family; required for transcription of glucose-repressed genes, thermotolerance, sporulation, and peroxisome biogenesis
Localization:
Intensity:
Fold change:
Significance:
-
C’ GFP library in SD
cytosol56.75 -
N' NOP1pr-GFP in SD
cytosol102.611 -
N' TEF2pr-mCherry in SD
cell periphery,vacuole59.6623 -
N' NATIVEpr-GFP in SD

cytosol64.4417 -
N' TEF2pr-VC and Cyto-VN in SD

#N/A0 -
C’ GFP library in SD+DTT
cytosol65.751.15No -
C’ GFP library in SD+H2O2

cytosol69.961.23No -
C’ GFP library in Starvation Media
cytosol54.820.96No -
C’ GFP library on the background of Pup2-DaMP

cytosol -
C’ GFP library on the background of CCT mutant

cytosol63.51761.11901No
